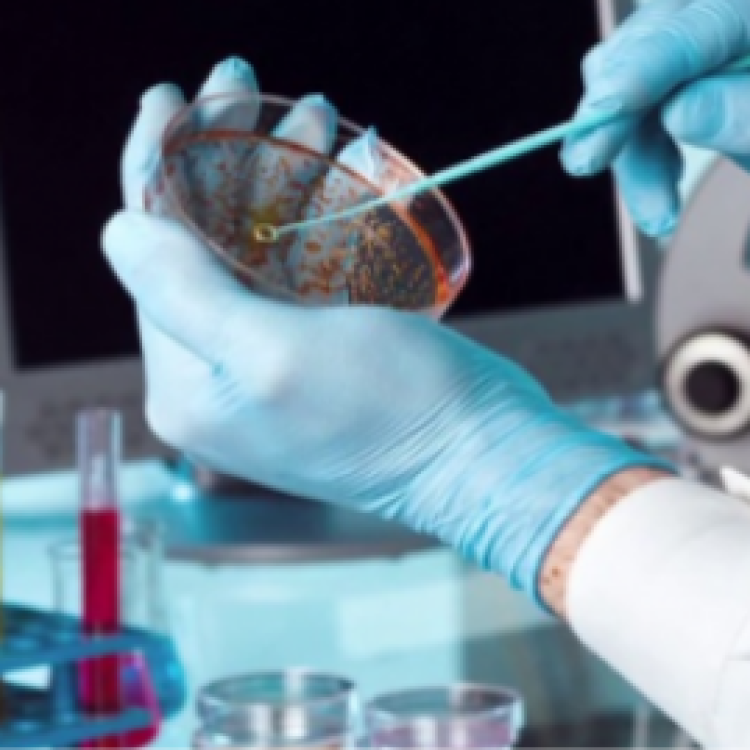
Department of Pharmaceutical Organic Chemistry

The Department of Pharmacology is one of the pre-clinical science departments that form Sciences division and is focused on basic life sciences research, undergraduate teaching of medicine and biomedical sciences students and the training and development of graduate study Pharmacology is the branch of pharmaceutical sciences which is concerned with the study of drug or medication action, where a drug can be broadly or narrowly defined as any man-made, natural, or endogenous (from within the body) molecule which exerts a biochemical or physiological effect on the cell, tissue, organ, or organism (sometimes the word pharmacon is used as a term to encompass these endogenous and exogenous bioactive species). More specifically, it is the study of the interactions that occur between a living organism and chemicals that affect normal or abnormal biochemical function. If substances have medicinal properties, they are considered pharmaceuticals.
Department vision
The Department of Pharmacology and Toxicology is looking forward to providing updated courses that contain advanced topics that will help the graduate of the Faculty of Pharmacy to compete in the international labor market.
Department mission
The mission of the Department of Pharmacology and Toxicology is to provide students with the information, knowledge and skills to deal with various toxins. For this reason, the department devotes its efforts to providing students with experience in the fields of society, hospitals, scientific research, and the pharmaceutical industry, as well as training in health care, in order to prepare a graduate who can practice the profession of pharmacy in Egypt efficiently.